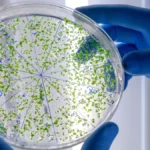

A Nemzeti Adatvédelmi és Információszabadság Hatóság (NAIH) átfogó vizsgálatot indított a Tisza Párt ellen, miután a párt adatbázisában több ezer magyar állampolgár személyes adatai szivárogtak ki. A Belügyminisztérium közleménye szerint a kiszivárgott adatok között szerepelnek személyi igazolvány számok, lakcímek és politikai preferenciára vonatkozó információk is.
Az adatvédelmi incidens múlt héten került napvilágra, amikor biztonsági szakértők felhívták a figyelmet, hogy a párt digitális kampányrendszerének súlyos biztonsági hiányosságai vannak. A vizsgálat eddigi eredményei arra utalnak, hogy a párt nem tartotta be az európai (GDPR) és a hazai adatvédelmi előírásokat, miközben több százezer állampolgár adatait gyűjtötte kampánycélokra. Szakértők szerint ez az eset az utóbbi évek egyik legsúlyosabb hazai adatvédelmi incidense.
„A személyes adatok ilyen mértékű gondatlan kezelése nem csak adatvédelmi bírságot, de súlyosabb esetben büntetőjogi következményeket is vonhat maga után” – nyilatkozta Dr. Kovács István, a Pécsi Tudományegyetem adatvédelmi szakjogásza. A Büntető Törvénykönyv 219. §-a szerint a személyes adattal visszaélés akár két év szabadságvesztéssel is büntethető.
A Tisza Párt közleményben reagált, amelyben „technikai hibára” hivatkoztak, és ígéretet tettek az érintettek értesítésére, valamint a rendszer teljes felülvizsgálatára. A párt vezetője, Hegyi Balázs ugyanakkor tagadta, hogy szándékos jogszabálysértés történt volna.
A kialakult helyzet komoly aggodalmat kelt a vidéki kistelepüléseken élők körében is, ahol a személyes adatok védelme különösen fontos érték. A Faluszövetség elnöke kiemelte: „Kisközösségekben az ilyen adatszivárgás súlyos bizalomvesztést okoz, és kiszolgáltatottá teszi a lakosságot.”
A hatóságok a vizsgálat lezárultáig fokozott éberségre és óvatosságra intik az állampolgárokat személyes adataik kezelése kapcsán, különös tekintettel a közelgő választásokra. A NAIH várhatóan a jövő hét folyamán teszi közzé első hivatalos állásfoglalását az ügyben, ami akár példátlan mértékű bírságot is jelenthet.